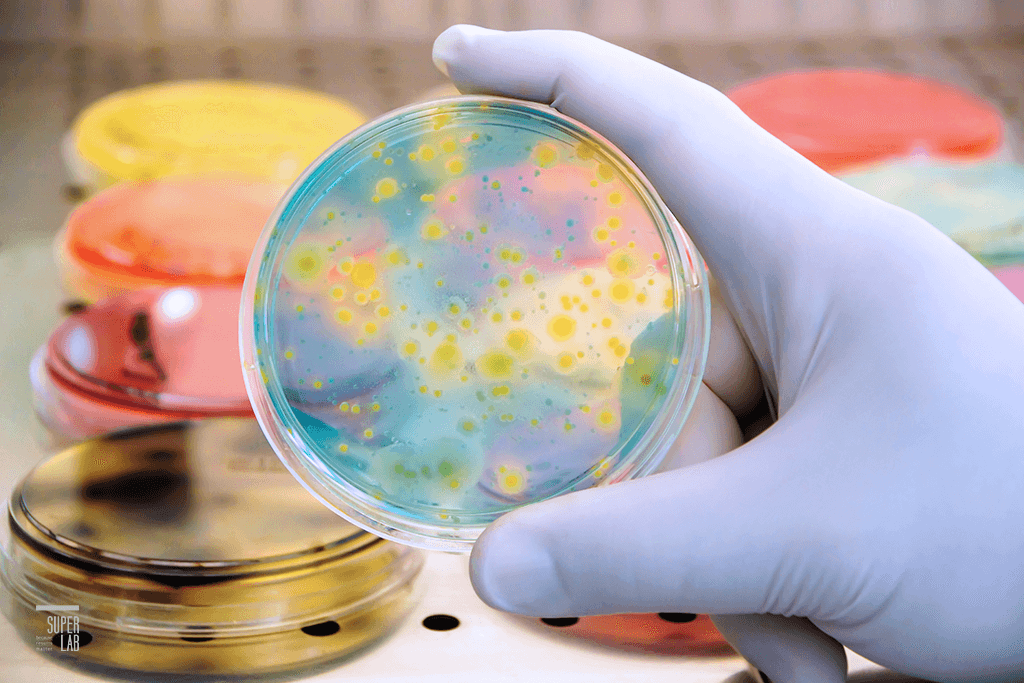

無菌試驗 (Sterility)
細胞治療產品於放行前皆須檢驗是否受細菌、真菌等微生物汙染,且應於製程確效階段時執行抑菌性與抑黴菌性試驗,確認其不會造成放行檢測中無菌試驗的偽陰性結果 (如使用抗生素)。細胞產品製造廠除可發展其他快速替代測試方法檢測細胞製品外,應定期確認與藥典中傳統培養法檢測結果之一致性。然而,細胞產品的品質保證仍須仰賴製造環境的嚴格管控與全製程的無菌操作技術執行來達成。

黴漿菌試驗 (Mycoplasma)
依據人類細胞治療產品查驗登記審查基準中規定,細胞庫與細胞治療產品應進行無菌性與黴漿菌測試,而當細胞治療產品之貯架期有限時,可接受以聚合酶鏈鎖反應(PCR)進行黴漿菌分析,然應執行確效試驗來證明所使用的 PCR 測試法,有足夠的敏感度與精確度。本中心使用 Sartorius Microsart® Mycoplasma Detection 黴漿菌檢測套組進行試驗,符合歐洲藥典 EP 2.6.7 之分析方法確效要求。
備註:
1. 檢品採樣時機及檢品詳細資訊由廠商自行提供。
2. 審查時應提供最近代表性 2 批次檢測結果。
可依汙染發生率選擇其它黴漿菌標準菌株進行確效。
- Mycoplasma gallisepticum ATCC 19610 (製程中使用禽類材料、禽類疫苗或培養物)
- Mycoplasma fermentans ATCC 19989 (人用疫苗或細胞庫)
- Mycoplasma hyorhinis ATCC 17981 (非禽鳥類之動物疫苗或細胞培養物)
- Mycoplasma synoviae ATCC 25204 (禽類材料、禽類疫苗或培養物)
- Mycoplasma arginini ATCC 23838
內毒素試驗(Endotoxins)
內毒素試驗為生物製劑、醫療注射用藥劑及植入性材料等產品,上市登記前必需檢附之安全品管資料,本司依據美國藥典(USP)第85章及FDA guideline規範,利用LAL(Limulus Amebocyte Lysate)試劑以動力呈色法檢測細菌內毒素含量,試劑靈敏度達0.005 EU/mL,取得FDA許可證及CE 標誌,試驗數據軟體符合FDA 21 CFR Part 11要求,並通過TFDA【GMP 委託檢驗】稽查,協助客戶完成上市前查驗登記,配合客戶研發與製程監控產線品質。

菌種鑑定 & 環境監測
依據 USP<1113> MICROBIAL CHARACTERIZATION, IDENTIFICATION, AND STRAIN TYPING,製程環境中的微生物監控至關重要,若自細胞產品的製程中或產品仍偵測到微生物,應進行鑑定甚至菌株分型,進而評估其對於成品的危害程度大小。
菌種鑑定流程
環境監測項目
- 環境微生物 (落菌) 測試。
- 無菌/無塵實驗室監控:HEPA 洩漏測試、溫濕度、風速、空氣懸浮微粒、紫外燈強度、落菌測試。
- 操作台/生物安全操作箱:入口氣流速度、氣流煙霧型態、排氣濾網洩漏、日光燈照度、噪音測試、振動測試。

你必須登入才能發表留言。